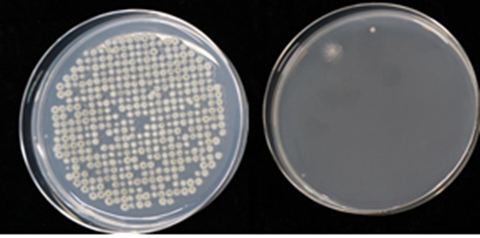

トルネックス(東京都中央区)はこのほど、同社が開発した電子式集塵フィルタが、窓開け換気などの際に室内に入ってくる“浮遊カビ”に高い捕集効果を発揮することを確認したと発表した。
浮遊真菌の除去性能検証試験は、カビの専門家である千葉大学真菌医学研究センター・矢口貴志准教授監修のもと実施。同社開発の電子式集塵フィルタ4種類すべてにおいて、フィルタを1回通過した時の浮遊真菌除去率が90%以上であることを確認したという。また、浮遊カビのほか、目に見えない様々な汚染物質(浮遊ウイルス、花粉、ホコリ、PM2.5、ダニ・カビなどのアレルゲンなど)を捕集することも確認できたとしている。
浮遊真菌の除去性能評価試験結果(左:捕集前、右:捕集後)。フィルタ1回通過で捕集率は型式CETX2001が99.7%(通過風量15m3/min)だった
同社の電子式集塵フィルタは、金属の極板を数ミリ間隔で積み重ねた構造で、極板に高電圧をかけて粉塵を吸着する仕組み。一般的なろ過式微小粒子フィルタと異なり、圧力損失が少なく目詰まりしにくい構造のため、空気の流れを妨げずに十分な風量を確保できるという。また、湿度やフィルタの汚れに応じて自動的に最適な運転を行うことで、使い始めと変わらない集塵性能を長期間安定的に維持できるという。
千葉大学の矢口貴志准教授は、カビを増やさないための環境づくりが大切だとしたうえで、「今回、電子式集塵フィルタにより、浮遊カビの捕集効果が確認されたことで、実生活環境においても空気中の浮遊カビ数を空気清浄により減少させる可能性があると期待できる」とコメントしている。
住宅ビジネスに関する情報は「新建ハウジング」で。試読・購読の申し込みはこちら。





























